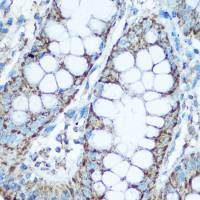
UQCRC2 antibody

相关产品推荐更多 >
万千商家帮你免费找货
0 人在求购买到急需产品
- 详细信息
- 文献和实验
- 技术资料
- 免疫原:
Full length of SARS-CoV-2 (COVID-19) nsp11 protein.
- 亚型:
IgG
- 形态:
Liquid
- 保存条件:
Store as concentrated solution. Centrifuge briefly prior to opening vial. For short-term storage (1-2 weeks), store at 4ºC. For long-term storage, aliquot and store at -20ºC or below. Avoid multiple freeze-thaw cycles.
- 克隆性:
Monoclonal
- 标记物:
Unconjugated
- 保质期:
12 months from the shipping date of the product.
- 抗原来源:
SARS Coronavirus 2
- 目录编号:
GTX638597
- 级别:
Primary Antibodies
- 库存:
Available
- 供应商:
GeneTex
- 宿主:
Rabbit
- 应用范围:
WB, ICC/IF
- 浓度:
1 mg/ml (Please refer to the vial label for the specific concentration.)
- 抗体英文名:
SARS-CoV-2 (COVID-19) nsp11 antibody [HL2388]
- 抗体名:
SARS-CoV-2 (COVID-19) nsp11 抗体 [HL2388]
- 规格:
100 μl/25 μl
| 规格: | 100 μl | 产品价格: | ¥4000.0 |
|---|---|---|---|
| 规格: | 25 μl | 产品价格: | ¥1700.0 |
SARS-CoV-2 (COVID-19) nsp11 antibody detects SARS-CoV-2 (COVID-19) nsp11 protein by immunofluorescent analysis.
Sample: Mock and transfected 293T cells were fixed in ice-cold MeOH for 5 min.
Green: GFP tagged protein is expressed in the transfected cells.
Red: SARS-CoV-2 (COVID-19) nsp11 stained by SARS-CoV-2 (COVID-19) nsp11 antibody (GTX638597) diluted at 1:500.
Blue: Fluoroshield with DAPI (GTX30920).
Non-transfected (–) and transfected (+) 293T whole cell extracts (30 μg) were separated by 15% SDS-PAGE, and the membrane was blotted with SARS-CoV-2 (COVID-19) nsp11 antibody (GTX638597) diluted at 1:5000. The HRP-conjugated anti-rabbit IgG antibody (GTX213110-01) was used to detect the primary antibody.
风险提示:丁香通仅作为第三方平台,为商家信息发布提供平台空间。用户咨询产品时请注意保护个人信息及财产安全,合理判断,谨慎选购商品,商家和用户对交易行为负责。对于医疗器械类产品,请先查证核实企业经营资质和医疗器械产品注册证情况。
文献和实验COVID-19 infection. Nature Scientifc Reports 2:MacMullan,MA et al. (2020) ELISA detection of SARS-CoV-2 antibodies in saliva. Nature Scientifc Reports 3:Hettegger,P et al. (2019) High similarity of IgG antibody profles in blood and saliva opens
高福院士团队 Lancet 发文:北京 COVID-19 病例分析表明,疫情爆发期间未出现新变种
城到动态清零政策,精准防控,阻止了新冠病毒的传播。随着 Omicron 亚变体致病性的减弱、疫苗接种的普及和防控经验的积累,2022 年 11 月中旬,中国调整和优化了预防和控制策略。 中国在调整防控政策后,疫情在中国的快速传播引起了世界的关注,并引发了人们对此次疫情是否会驱动新 SARS-CoV-2 变体出现的担忧。因此,对流行的 SARS-CoV-2 变体进行全面的时空研究,对于全球应对当前的 COVID-19 大流行至关重要。北京拥有常住人口 2100 万,在政策调整后初期成为中国病例
IF 44!哈佛最新研究:坚持 6 种健康生活方式,长新冠风险可降低一半
方式与降低长新冠的风险有关,简单的生活方式改变,例如充足的睡眠,就可以预防长新冠。 图片来源:JAMA Internal Medicine 「随着 COVID-19 的持续浪潮,Long COVID 造成了严重的公共卫生负担。我们的研究结果提出了采取更健康的生活方式可能会降低患 Long COVID 的风险的可能性。」该研究的资深作者 Andrea L. Roberts 表示。 研究人员分析了 32000 多名女护士的数据,记录了她们的生活方式和在 2020 年 4 月到 2021 年 11 月
技术资料暂无技术资料 索取技术资料







![Nanog antibody [N3C3]](https://img1.dxycdn.com/2022/0328/706/7347160733863200453-14.jpg!wh200)